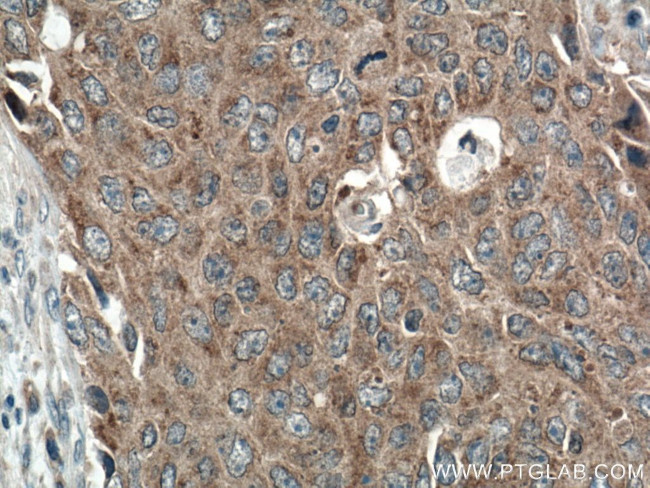
LRRC8A/SWELL1 Antibody in Immunohistochemistry (Paraffin) (IHC (P))

Search
Proteintech
LRRC8A/SWELL1 Polyclonal Antibody
{{$productOrderCtrl.translations['antibody.pdp.commerceCard.promotion.promotions']}}
{{$productOrderCtrl.translations['antibody.pdp.commerceCard.promotion.viewpromo']}}
{{$productOrderCtrl.translations['antibody.pdp.commerceCard.promotion.promocode']}}: {{promo.promoCode}} {{promo.promoTitle}} {{promo.promoDescription}}. {{$productOrderCtrl.translations['antibody.pdp.commerceCard.promotion.learnmore']}}


Please note: We are reviewing Western blot images included in the antibody testing data in our catalog, including those provided by third parties. Unless expressly labeled or annotated as “raw-unedited”, Western blot images included in the antibody testing data in our catalog may have been edited, optimized or otherwise adjusted for presentation.
产品信息
17155-1-AP150UL
种属反应
宿主/亚型
分类
类型
偶联物
形式
浓度
规格
纯化类型
保存液
内含物
保存条件
运输条件
靶标信息
Essential component of the volume-regulated anion channel (VRAC, also named VSOAC channel), an anion channel required to maintain a constant cell volume in response to extracellular or intracellular osmotic changes. The VRAC channel conducts iodide better than chloride and may also conduct organic osmolytes like taurine. It is unclear whether LRRC8A constitutes a pore-forming subunit or whether it is closely associated with the pore and mediates channel properties such as ion selectivity. Involved in B-cell development: required for the pro-B cell to pre-B cell transition. Also required for T-cell development.
仅用于科研。不用于诊断过程。未经明确授权不得转售。
篇参考文献 (0)
生物信息学
蛋白别名: HsLRRC8A; Leucine-rich repeat-containing protein 8A; Swelling protein 1; Volume-regulated anion channel subunit LRRC8A
基因别名: KIAA1437; LRRC8; LRRC8A; SWELL1; UNQ221/PRO247
Entrez Gene ID: (Human) 56262